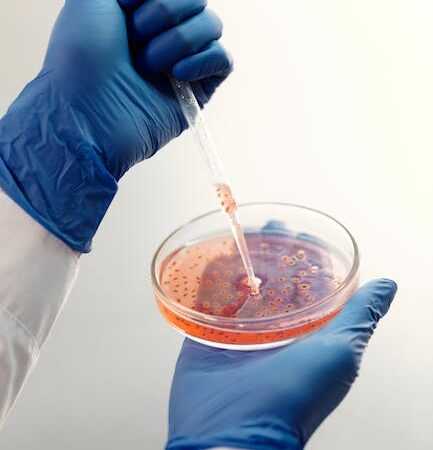

Odpowiedni sprzęt laboratoryjny to gwarancja wydajnej i precyzyjnej pracy. Jedną z kluczowych rzeczy są pipety. Na rynku mamy kilka rodzajów pipet. Mamy pipety Pasteura, serologiczne wielomiarowe oraz automatyczne. Czym charakteryzuje się każdy z poszczególnych rodzajów? W tym poradniku dowiesz się, do jakich czynności są dedykowane wymienione pipety. Dzięki takiej wiedzy sprawnie wybierzesz odpowiedni sprzęt. Zapraszamy!
Kiedy najlepiej sprawdzą się pipety plastikowe Pasteura i dlaczego są lepsze od szklanych?
Pipety Pasteura nazywane często również pipetami transferowymi to najprostszy rodzaj pipet dostępnych na rynku. Wykorzystuje się je przy czynnościach, które nie wymagają idealnej precyzji. Sprawdzają się przy przenoszeniu cieczy, odciąganiu jej nadmiaru oraz dozowaniu. W ten rodzaj pipet wyposażony jest praktycznie każde laboratorium. Stosuje się je w branży chemicznej, biologicznej, medycznej i farmaceutycznej. W przypadku pipet Pasteura mamy do wyboru dwa rodzaje materiałów, z którego mogą być wykonane. Jeden z nich przewyższa pod kilkoma względami drugi.
Plastikowe pipety Pasteura nie wymagają sterylizacji po każdym użyciu, co jest niezbędne przy pipetach szklanych. Ponadto stosując pipety plastikowe, można się w pełni skupić na wykonywanym zadaniu. Plastik wyklucza możliwość zbicia się narzędzia oraz zapewnia pewniejszy chwyt. Ponadto plastikowe pipety są wykonane z najwyższej jakości materiałów medycznej klasy. To wszystko sprawia, że laboratoria coraz chętniej przerzucają się ze szklanych rozwiązań na pipety plastikowe.
Jakie zastosowania mają pipety serologiczne wielomiarowe?
Takie pipety są znacznie precyzyjniejsze niż pipety Pasteura. Charakteryzują się bardzo dokładną podziałką, która sprawia, że praca jest efektywna. Dlatego używa się ich do zadań wymagających idealnej precyzji. W przypadku pipet wielomiarowych ważny jest materiał, z którego są wykonane.
Najwyższej jakości pipety serologiczne wielomiarowe są wykonane ze szkła sodowego. To materiał o niewielkiej rozszerzalności cieplnej. Takie nacechowanie sprawia, że pipeta umożliwia pomiary w szerokim zakresie temperatur. Ponadto bardzo łatwo dobrać pipetę pod dane laboratorium. To ze względu na szeroki wybór pojemności. Na rynku bez problemu znajdziesz pipety serologiczne wielomiarowe o pojemności od 1 ml do nawet pół litra.
Dlaczego warto postawić na pipety automatyczne?
Pipeta automatyczna składa się z tłoczka, rączki, regulatora oraz wymiennej końcówki, która może mieć różne pojemności. Ciecz pobierana jest jedynie do końcówki. Te najczęściej są wykonane z polietylenu lub teflonu. Końcówki do pipet automatycznych można kupić w pakiecie nawet kilku tysięcy sztuk, dzięki czemu nie trzeba regularnie sprawdzać laboratoryjnych zapasów sprzętu. Pipety automatyczne sprawiają, że praca jest szybka i maksymalnie precyzyjna. Taki sprzęt umożliwia odmierzanie cieczy nawet od kilku dziesiątych części mililitra aż do kilkudziesięciu mililitrów. Dlatego stosuje się go głównie przy pracach, gdzie nie ma miejsca na najmniejszy błąd. Pracę z pipetami automatycznymi ułatwia również opcja automatycznego zrzutu końcówek. Warto jednak pamiętać, że nie każda pipeta automatyczna jest wyposażona w taki mechanizm. Przed wyborem konkretnego sprzętu, warto dokładnie zapoznać się z jego specyfikacją. Tam z pewnością znajdziesz szczegółowe informacje o oferowanych udogodnieniach.
Jak wybrać pipety? Podsumowanie
Wybór odpowiednich pipet zależy w głównej mierze od zastosowania sprzętu. W tym poradniku poznałeś specyfikę używania poszczególnych rodzajów pipet. Wybierz sprzęt laboratoryjny zgodnie z poznaną wiedzą, a z pewnością będziesz zadowolony z zakupu.